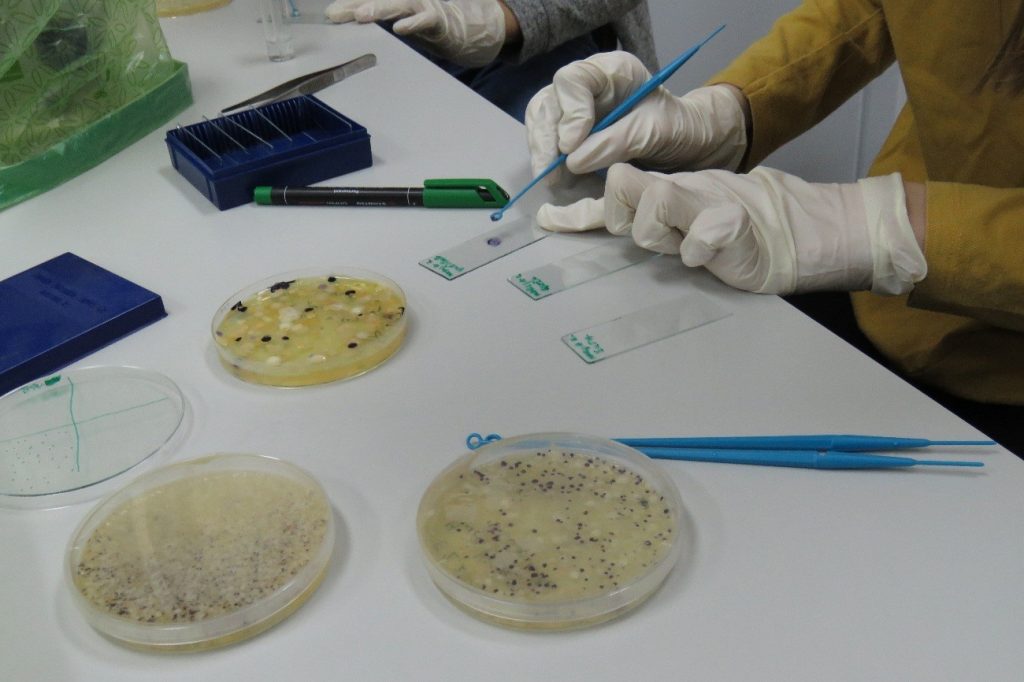

Uvod, materijali i metode, rezultati i zaključak – stavke su pravog znanstvenog rada. Mnogi se s njima upoznaju tek u višim razredima srednjih škola ili na fakultetima. No, da tomu nije uvijek tako najbolje pokazuje PANDA 3 – projektna nastava za darovitu djecu, u kojemu darovita djeca imaju priliku provesti pravo znanstveno istraživanje i napraviti znanstveni rad. U tome im pomažu razni stručnjaci iz privatnog, javnog ili civilnog sektora. O čemu je točno riječ i kako to sve izgleda saznajte u slijedećim redcima!
Ovaj uspješan i izniman projekt, koji spaja znanstvenike, brojne volontere iz različitih sektora, kako bi darovitoj djeci pružio nastavu sukladno njihovim potrebama, već treću godinu zaredom provodi Bioteka – udruga za promicanje biologije i srodnih znanosti. Pod nazivom PANDA 3 – projektna nastava za darovitu djecu, ove godine priliku za sudjelovanjem u ovom projektu dobili su učenici iz dvije osnovne, zagrebačke škole – Fran Galović i Gustav Krklec.
Aktivnosti projekta započele su u prosincu 2018. te se odvijaju tijekom cijele školske godine kroz redovite radionice i istraživanja u udruzi Bioteka ili na fakultetima i ustanovama poput Agronomskog i Prehrambeno-biotehnološkog fakulteta i Zoološkog vrta grada Zagreba. Daroviti učenici iz naše škole, njih 16, istraživali su i uzgajali bakterije na Prehrambeno-biotehnološkom fakultetu. Uzorke su uzimali iz vode, sa „žoharovih leđa“, leća naočala, objektiva fotoaparata i sa mnogih drugih površina kojih su se dosjetila. Uz pomoć vrijednih studentica iz USKA-e (Udruga studenata krajobrazne arhitekture) raspravljali su o planskom i neplanskom naselju, utjecaju željezničke pruge na obližnje stambene zgrade, zahvatima u prostoru te naučili koje su poveznice između škola i staračkih domova sa zabavnim parkovima, fitnes centrima i muzejima.
Nakon proljetnog odmora, projekt se nastavio uz brojna druga istraživanja: što je to hidroponski uzgoj, mogu li biljke rasti bez zemlje, što je to obogaćivanje životnog prostora i što važnog za život trebaju prstenastorepi lemuri, merkati, kapucini i nosati rakuni, samo su neka od aktualnih pitanja kojima se upravo bave vrijedni školarci. Rezultate njihova istraživanja očekujemo u lipnju, kada ćemo vas izvijestiti i o ostalim rezultatima ovog projekta.

Ima li bakterija na objektivu fotoaparata? 
Učenici su raspravljali gdje treba sagraditi starački dom, gdje reciklažno dvorište, a gdje školu? 
Rasprava o planskoj i neplanskoj izgradnji te utjecaju željezničke pruge na obližnje stambene zgrade?
Nakon što su kolonije bakterija iz uzorka vode narasle, učenici su na PBF-u napravili mikroskopski preparat 
Učenici su na kartama tražili svoju školu, kuću ili stan 
Nakon provedenog istraživanja na PBF-u, učenici su izradili znanstvene plakate koje će prezentirati kolegama u razredu i školi 
Izrada hranilice za obogaćivanje životnog prostora prstenastorepih lemura Zoološkog vrta grada Zagreba 
Briga za biljke u hidroponskom uzgoju
